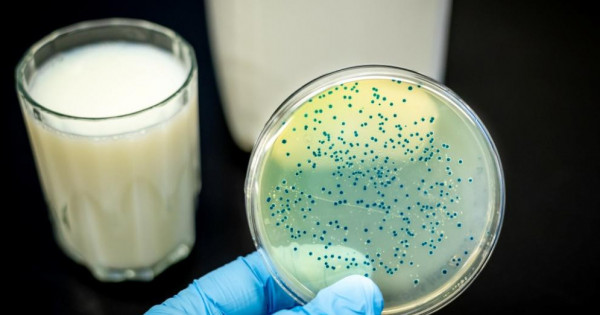

برۋتسەللەزدى جۇقتىرۋ جاعدايلارىنىڭ 66,6%-ىندا تاماققا قايناتىلماعان ءسۇت جانە ءسۇت ونىمدەرىن پايدالانۋ سەبەپ بولعان.
سونداي-اق دەرتكە شالدىققانداردىڭ باسىم بولىگى سول ءسۇت ونىمدەرىن جەكە تۇلعالاردان ساتىپ العانىن ايتادى.
ال قالعان 33,3% جاعدايدا ءتورت ت ۇلىكتى اسىراۋ كەزىندە سانيتاريالىق-گيگيەنالىق نورمالاردى بۇزۋ, جانۋارلاردى ۋاقتىلى زەرتحانالىق تەكسەرۋدەن وتكىزبەۋىنەن برۋتسەللەز جۇقتىرعان.
برۋتسەللەزدىڭ ءۇي وشاقتارىنان الىنعان سىنامالاردا ينفەكتسيا قوزدىرعىشتارى 7,8%-ىندا ءسۇت ونىمدەرىنەن, 1,1%-ىندا تەزەكتەن, 2,2%-ىندا شوپتەن, 1,1%-ىندا جۇننەن انىقتالعان.
بۇل زەرتتەۋ ناتيجەسى ميكروبتاردىڭ قورشاعان ورتاعا تارايتىنىن كورسەتەدى. ول ءوز كەزەگىندە ينفەكتسيانىڭ تارالۋ فاكتورى بولۋى مۇمكىن.
«بيىل شەت, بۇقار جىراۋ, اباي, اقتوعاي جانە وساكاروۆ اۋداندارىندا ادامدار ءۇشىن برۋتسەللەز قوزدىرعىشىنىڭ نەگىزگى كوزدەرى سانالاتىن ءىرى قارا جانە ۇساق مال اراسىندا وسى دەرتتىڭ 391 جاڭا ەپيزووتيالىق وشاعى انىقتالعان», دەپ مالىمدەدى قاراعاندى وبلىسىنىڭ سانيتارلىق-ەپيدەميولوگيالىق دەپارتامەنتى.
ايانا توعانبەك





































